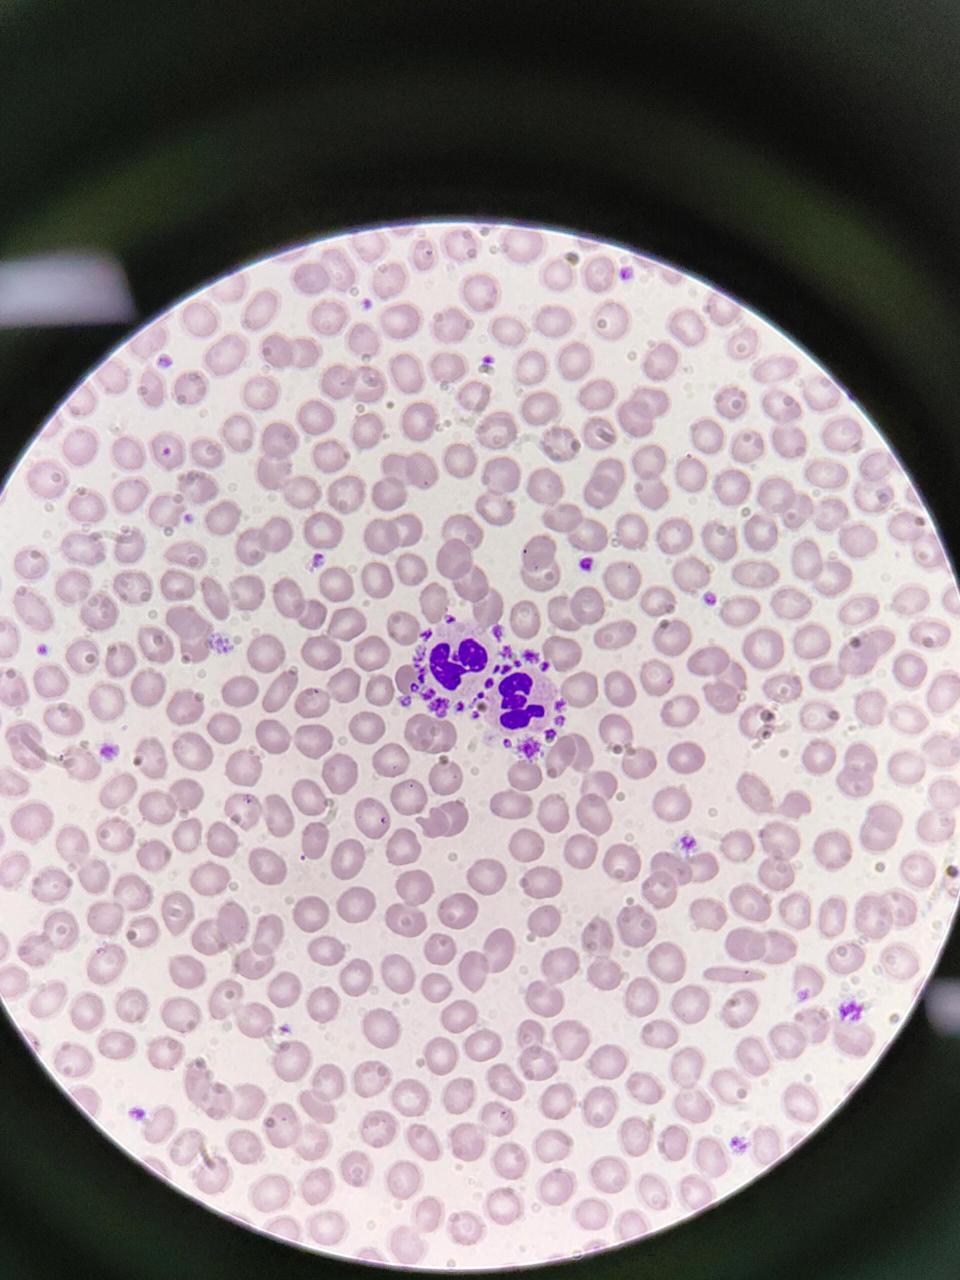
血小板卫星现象959595 97血小板卫星现象:血小板黏附,围绕于
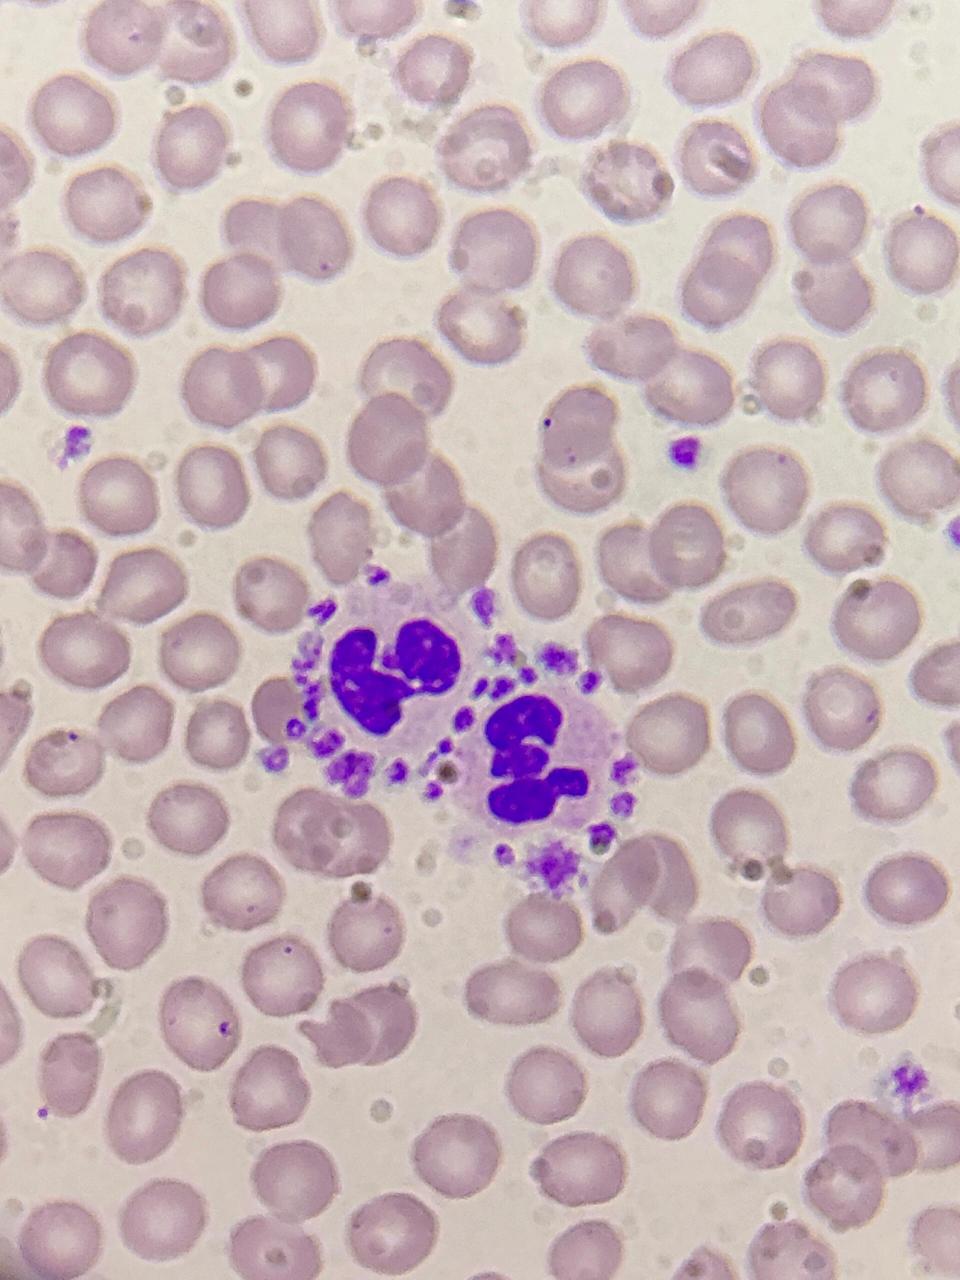
血小板卫星现象959595 97血小板卫星现象:血小板黏附,围绕于
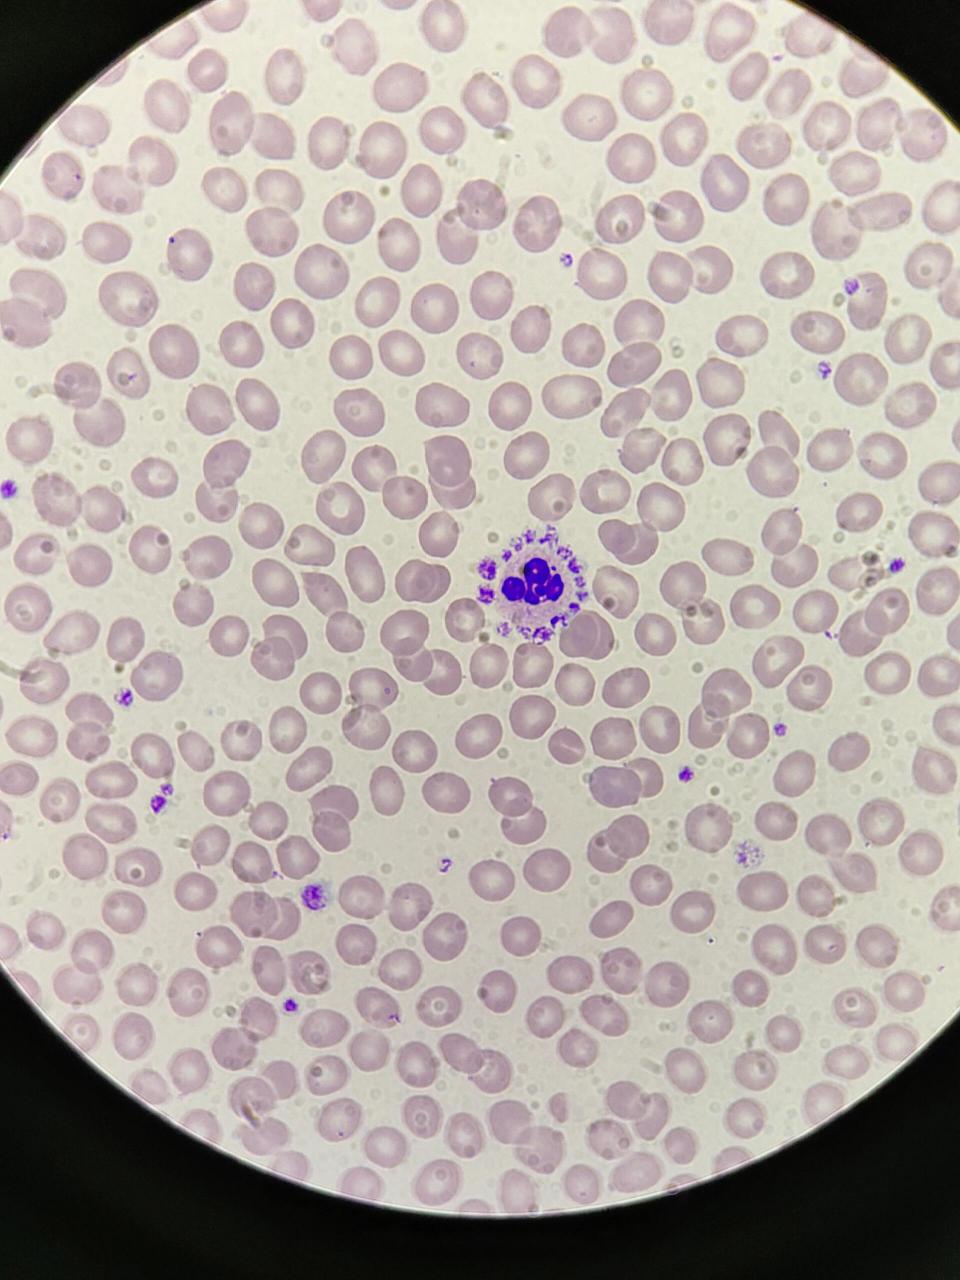
血小板卫星现象959595 97血小板卫星现象:血小板黏附,围绕于
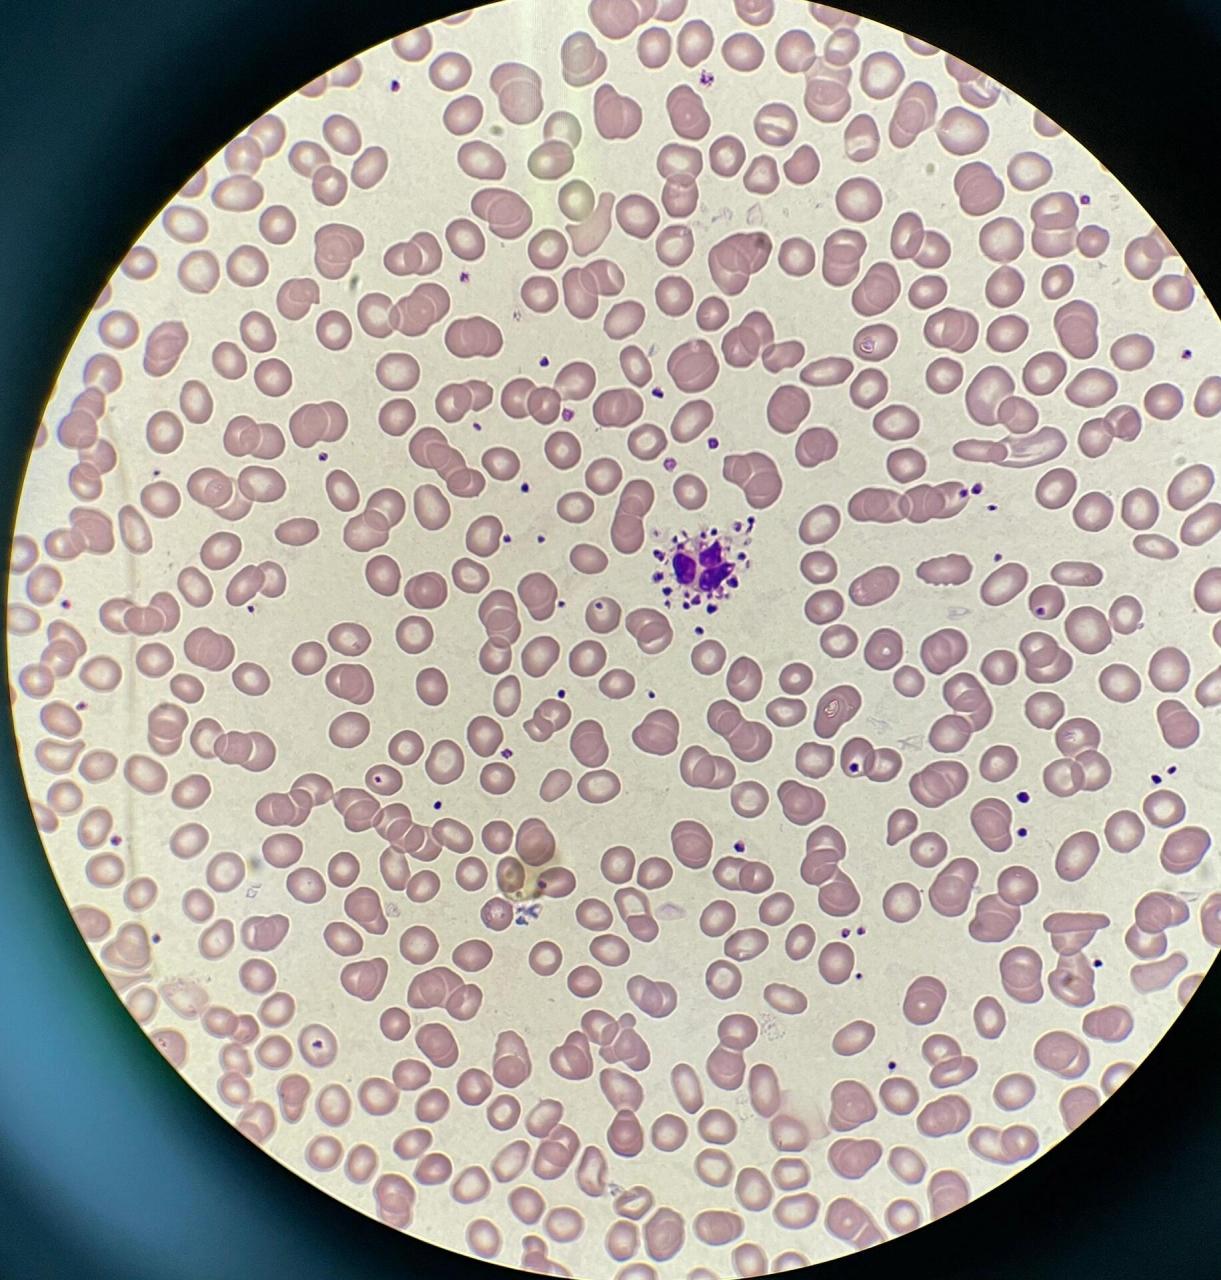
0615血小板卫星现象 99血小板卫星现象是血小板粘附,围绕于中性
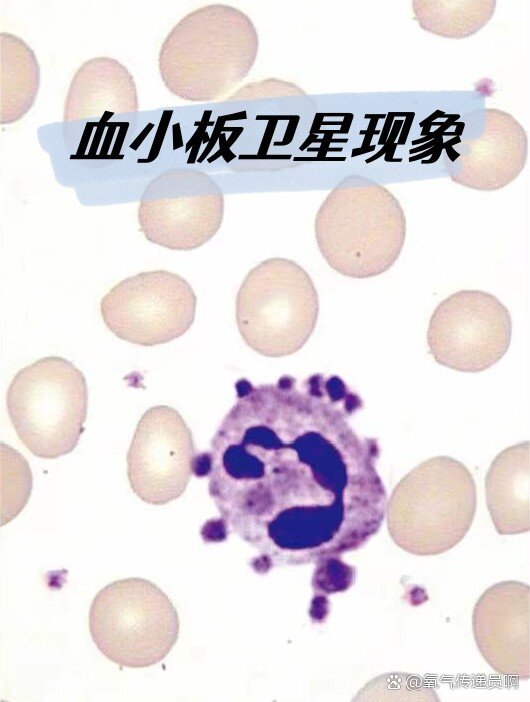
血小板卫星现象
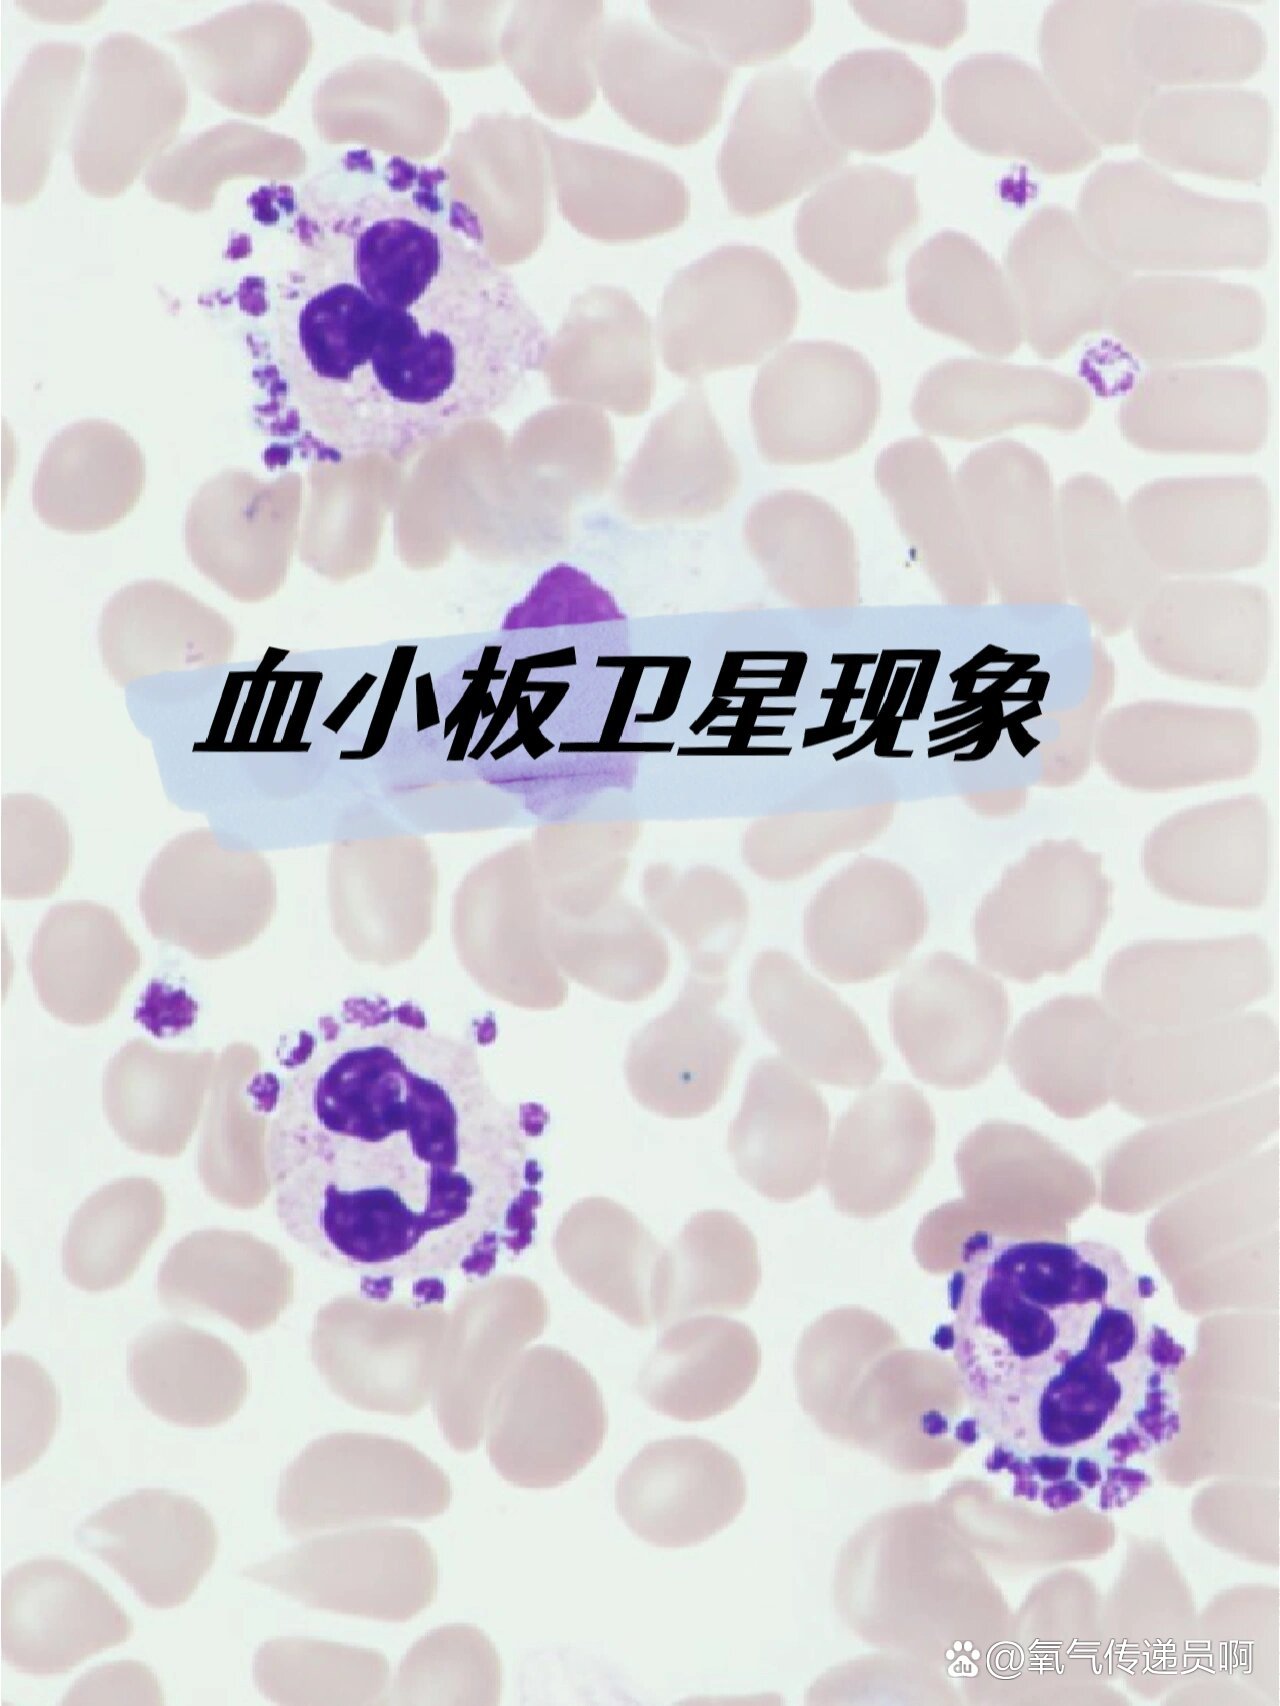
血小板卫星现象
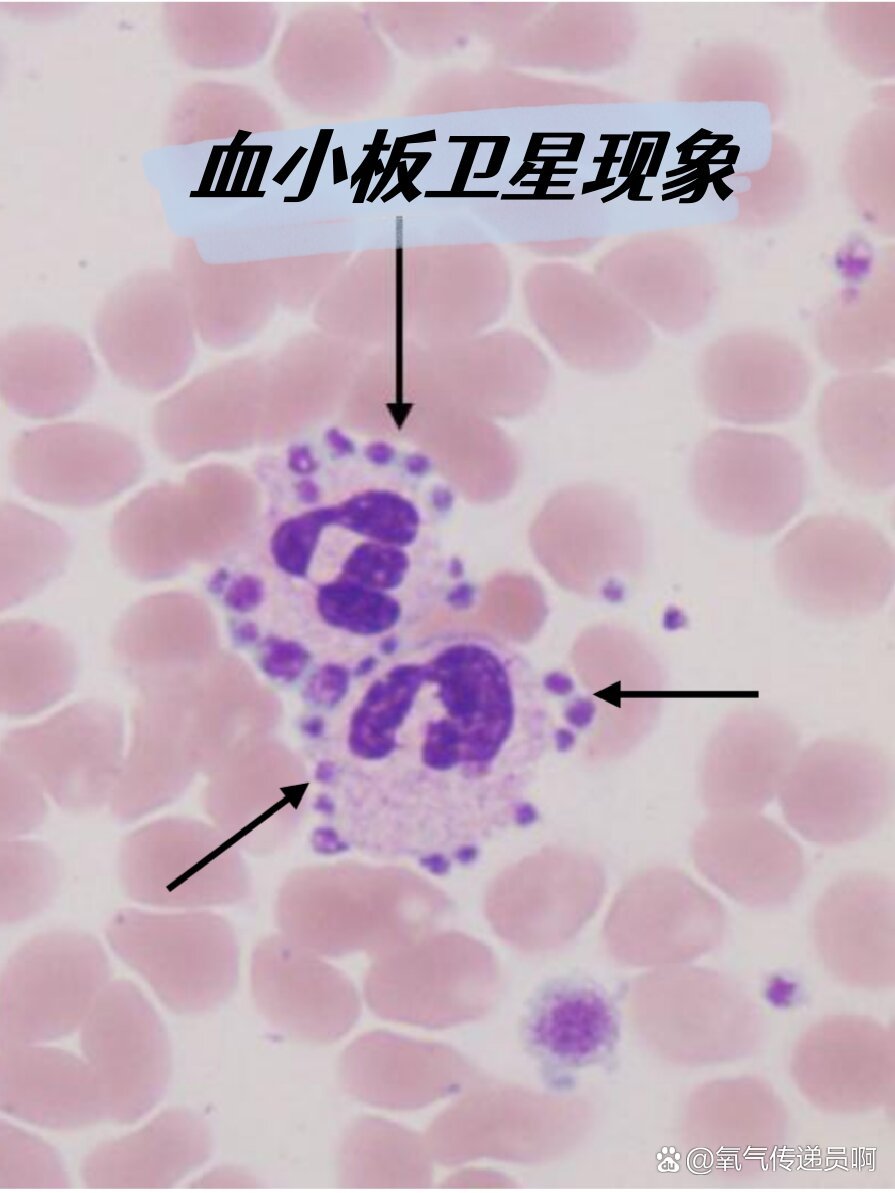
血小板卫星现象
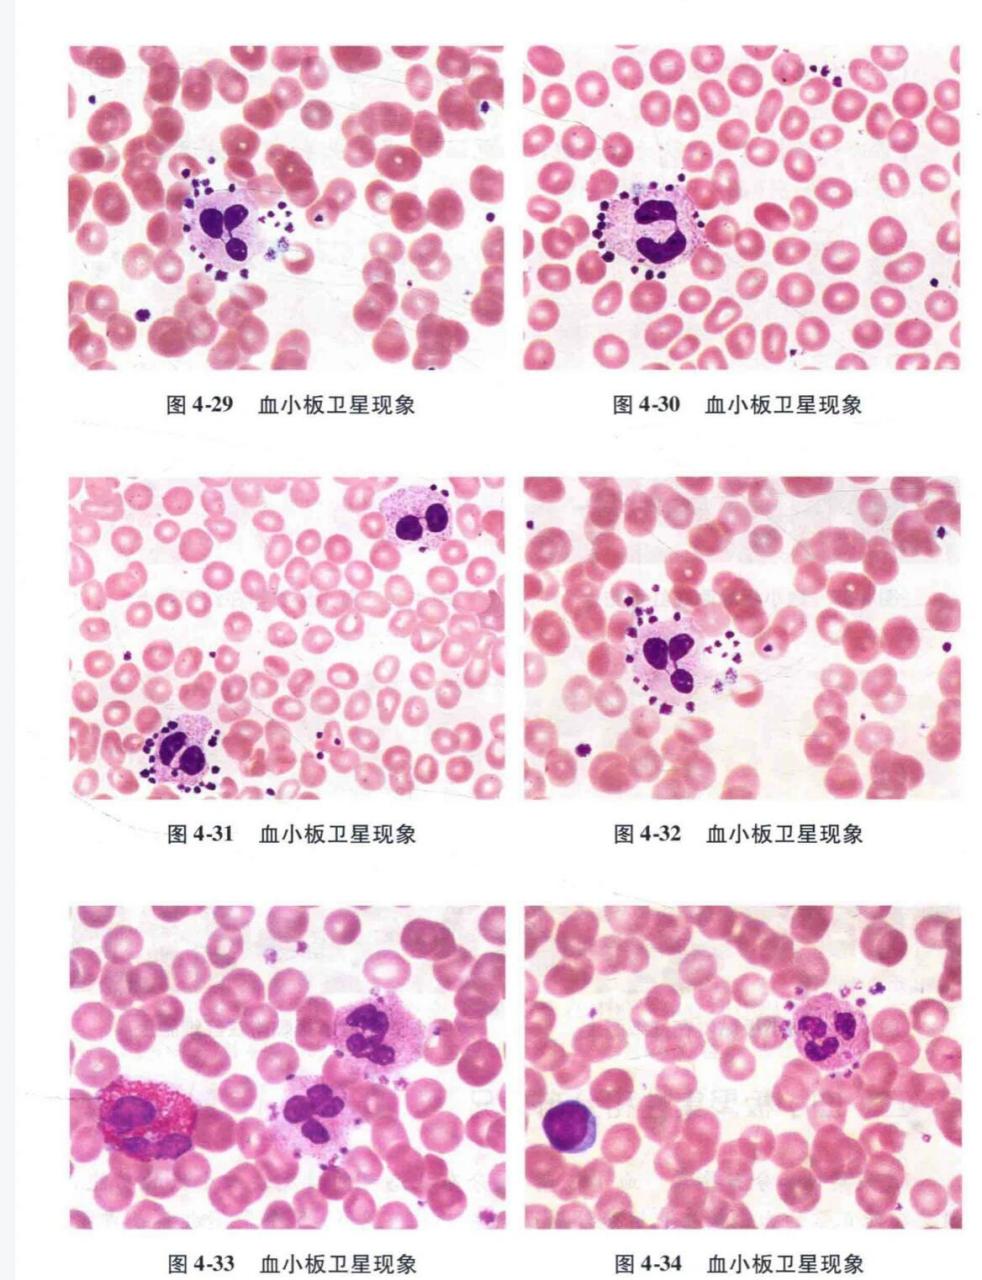
0615血小板卫星现象 99血小板卫星现象是血小板粘附,围绕于中性

血小板卫星现象图片

血小板卫星现象959595 97血小板卫星现象:血小板黏附,围绕于
图片尺寸960x1280
血液形态学之血小板卫星现象
图片尺寸3024x4032
血小板卫星现象959595 97血小板卫星现象:血小板黏附,围绕于
图片尺寸960x1280
血小板卫星现象959595 97血小板卫星现象:血小板黏附,围绕于
图片尺寸960x1280
记一例edta导致的血小板卫星现象
图片尺寸612x751
记一例edta导致的血小板卫星现象
图片尺寸1000x1333
血小板卫星现象
图片尺寸600x400
记一例edta导致的血小板卫星现象
图片尺寸1000x1333
种豆得瓜,一例血小板卫星现象发现之旅并纠正法宝
图片尺寸320x329
血小板卫星现象#形态学介绍 95血小板卫星现象(platelet satelliti
图片尺寸1280x800
0615血小板卫星现象 99血小板卫星现象是血小板粘附,围绕于中性
图片尺寸1221x1280
血小板卫星现象
图片尺寸530x702
血小板卫星现象
图片尺寸1280x1706
血小板卫星现象见于妊娠,自身免疫性疾病,behcet病及血栓栓塞等有关
图片尺寸300x300
血小板卫星现象#形态学介绍
图片尺寸1080x675
肿瘤性淋巴细胞胞质碎片周围的血小板卫星现象
图片尺寸478x244
血小板卫星环绕现象
图片尺寸1599x1199
血小板卫星现象
图片尺寸895x1193
答案: :血小板卫星现象(edta盐所致,血常规数据中会出现假性血小板
图片尺寸1078x1078
0615血小板卫星现象 99血小板卫星现象是血小板粘附,围绕于中性
图片尺寸982x1280